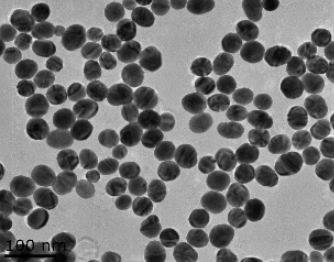
PEG化磁性锌锰铁氧体(甲氧基末端) PEG化磁性锌锰铁氧体(甲氧基末端)

PEG化磁性锌锰铁氧体(甲氧基末端)
产品名称:PEG化磁性锌锰铁氧体(甲氧基末端)
产品描述:
PEG化磁性锌锰铁氧体(甲氧基末端)
【产品分类】
PEG化磁性锌锰铁氧体(甲氧基末端)
电镜尺寸约7-10 nm
水动力尺寸(MnxZn1-xFe2O4内核+包覆层+表面水化层直径)约30±5 nm。
饱和磁化强度约80±10 emu/g铁
产品名称 | 规格 | 铁浓度 |
PEG化磁性锰锌铁氧体纳米晶(甲氧基末端) | 2.5 mL | 1 mg/mL |
5 mL | 1 mg/mL | |
10 mL | 1 mg/mL |
【性状】:黑色液体
【特点】
l1.好的水溶性
2.抗巨噬细胞吞噬
3.可体内长循环
4.具有肿瘤被动靶向性
【用途】
利用羧基末端偶联相应抗体构建靶向纳米探针,用于
lMRI靶向造影及分子影像研究
lMRI/光学双模态造影及分子影像研究
l磁感应肿瘤热疗研究
l靶向药物载体
相关产品:
靶向修饰的龙葵碱白蛋白纳米粒
甘草酸偶联牛血清白蛋白载木犀草素纳米粒
靶向功能的阿霉素/白蛋白-葡聚糖纳米粒子
新型白蛋白-siRNA复合纳米颗粒
环孢素A白蛋白纳米粒(CyA-HSA)
磁性阿霉素白蛋白纳米粒
紫杉醇白蛋白纳米粒
多西紫杉醇白蛋白纳米粒
半乳糖化白蛋白磁性阿霉素纳米粒(Gal-MADM-NP)
叶酸偶联米托蒽醌白蛋白纳米粒(MTO-BSANP-folate)
受体介导米托蒽醌白蛋白纳米粒
温馨提醒:仅供科研,不能用于人体实验
联系我们:
邮箱:2519696869@qq.com
QQ: 2519696869
电话:18066853083
微信:18066853083
公司介绍:
西安齐岳生物科技有限公司是集化学科研和定制与一体的高科技化学公司。业务范围包括化学试剂和产品的研发、生产、销售等。涉及产品为通用试剂的分销、非通用试剂的定制与研发,涵盖生物科技、化学品、中间体和化工材料等领域。
主营产品:COF、MOF单体系列:三蝶烯衍生物、金刚烷衍生物、四苯甲烷衍生物、peg、上转换、石墨烯、光电材料、点击化学、凝集素、载玻片、蛋白质交联剂、脂质体、蛋白、多肽、氨基酸、糖化学等。


